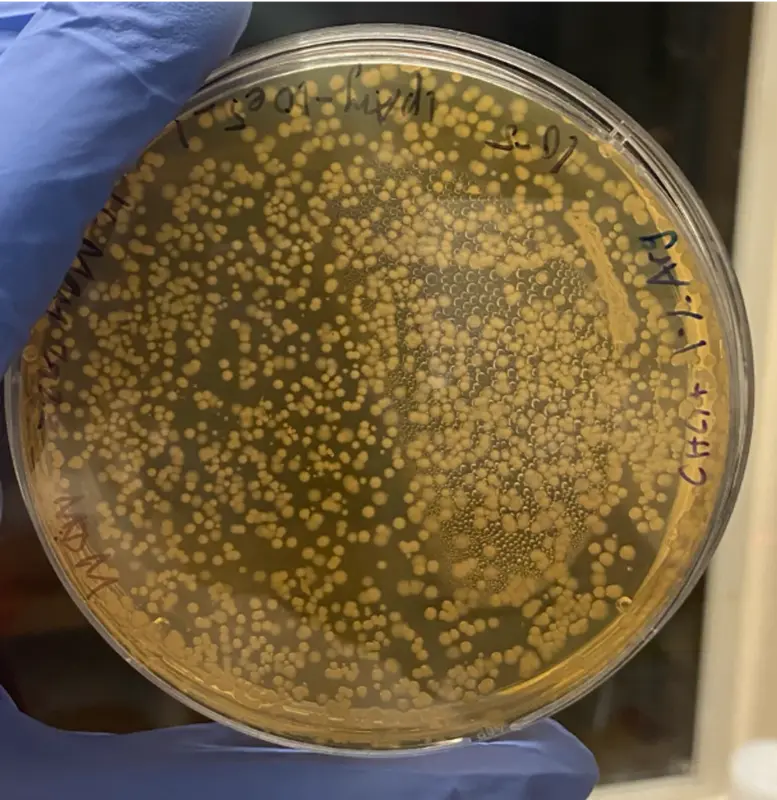
Бактерии кишечника повышают уровень половых гормонов

Ученые раскрыли механизм, с помощью которого кишечные бактерии превращают молекулы в желчи в половые гормоны.
Кишечник предоставляет бактериям множество питательных веществ. Помимо пищи, глюкокортикоиды, содержащиеся в желчи, являются важным субстратом для микробов. Бактерии могут превращать эти стероиды в различные метаболиты, влияющие на системы хозяина. В исследовании, опубликованном недавно в журнале Cell, ученые показали, что некоторые кишечные бактерии могут вырабатывать половые гормоны, включая прогестины. Исследователи ранее показали, что прогестины регулируют менструальный цикл и беременность, а также изменяют активность нейронов. Данное исследование - первое сообщение о производстве прогестинов бактериями. "Я постоянно удивляюсь масштабам влияния микробов кишечника на организм хозяина, но, возможно, мне уже не стоит удивляться", - делится Джерард Кларк, нейробиолог, изучающий ось „кишечник-мозг“ в Университетском колледже Корка.
На протяжении большей части своего жизненного пути Слоан Девлин готовилась стать химиком. Однако, став постдокторантом в лаборатории, изучающей взаимодействие хозяина и микробиома, она увидела возможность для специалиста с химическим образованием прояснить влияние бактериальных молекул на хозяина. «Есть химики, которых больше привлекают физические науки и науки о материалах, а есть химики, которых больше привлекает биология», - говорит Девлин. «Меня всегда больше тянуло к биологии». Сейчас в своей лаборатории в Гарвардской медицинской школе Девлин пытается понять механизмы, с помощью которых кишечные бактерии влияют на неврологические функции и поведение.
Просматривая литературу в поисках информации о том, как кишечные бактерии метаболизируют глюкокортикоиды, авторы исследования поняли, что с начала 1980-х годов новых данных по этой теме практически нет - 40-летний пробел в знаниях. Некоторые исследователи сообщали, что кишечные бактерии могут превращать эти молекулы в половые гормоны. Однако, поскольку эти исследования проводились до появления современной генетики, не было никакой информации ни о штаммах бактерий, ни о генах, участвующих в этом процессе. В те времена исследователям требовалось от 5 до 50 миллилитров желчи, чтобы выделить несколько микролитров стероидов. Из-за строгих правил защиты пациентов получение таких больших объемов у пациентов теперь невозможно. Поэтому Девлин был вынуждена разработать методику извлечения и измерения уровня биомолекул из ограниченного и ценного количества желчи.
Для этого Девлин объединилась с Меган МакКерри, микробиологом из биотехнологической компании Holobiome и соавтором исследования. МакКерри потратила пять лет на разработку высокочувствительного метода хроматографии, который требует в 500 раз меньшего объема желчи, чем предыдущие анализы. Ее метод также оказался эффективным при разделении и количественном определении стероидов, которые очень сильны и поэтому присутствуют в ничтожных количествах. Используя усовершенствованную методику, МакКерри обнаружила, что некоторые глюкокортикоиды содержатся в желчи человека в большем количестве, чем другие. Больше всего авторов заинтриговала группа глюкокортикоидов, которые могут превращаться в прогестины, принадлежащих к классу половых гормонов.
Чтобы выяснить, могут ли кишечные бактерии осуществлять эту химическую реакцию, исследователи собрали фекалии мышей с кишечными бактериями и без них и культивировали образцы с глюкокортикоидами. Фекалии служат косвенным показателем микробиома кишечника и его продуктов. Девлин и ее коллеги обнаружили прогестины только в фекалиях мышей с микробиомом кишечника, что говорит о том, что бактерии играют ключевую роль в производстве гормона.

Воздействие на бактерии Eggerthella lenta газообразным водородом (в желтых шариках) заставило их вырабатывать прогестин из глюкокортикоидов. Фото: Megan McCurry, Harvard Medical School Electron Microscopy Facility.
Девлин хотела выделить вид бактерий, ответственный за превращение глюкокортикоидов в прогестины. Основываясь на предыдущих исследованиях, которые показали, что вид Eggerthella lenta может осуществлять эту реакцию, Девлин и ее сотрудники протестировали различные штаммы бактерий. Однако они так и не смогли наблюдать за производством прогестинов. Поэтому ученые решили выделить этот вид из человеческих фекалий. Они культивировали человеческие фекалии с аминокислотой, которая стимулирует рост E. lenta и ее родственников, и искали бактерии, вырабатывающие прогестин. Хотя микробиом кишечника человека содержит от 300 до 500 различных видов бактерий, только одна из них, Gordonibacter pamelaeae, справлялась с этой задачей, хотя и слабо. Однако когда они выращивали G. pamelaeae вместе с кишечным комменсалом E. coli Nissle 1917 (EcN), это значительно улучшало производство прогестина. Двенадцать других бактериальных штаммов из того же семейства - Eggerthellaceae - обрели способность производить прогестины при совместном культивировании с EcN.
Было ясно, что EcN имеет решающее значение для химической реакции, поэтому Девлин предположила, что он может создавать благоприятные условия для производства прогестинов одним из трех способов: снижая окислительно-восстановительный потенциал среды, необходимой для реакции, физически взаимодействуя с другими бактериями для совместного метаболизма или выделяя внеклеточные агенты, которые повышают активность бактерий.
Они проверили каждый из этих сценариев на примере E. lenta, родственника G. pamelaeae, которого ученые могут генетически модифицировать. После опровержения первых двух теорий у исследователей наступил момент эврики. Проверяя воздействие внеклеточных агентов, они извлекли надосадочную жидкость из культур EcN и отфильтровали ее, чтобы удалить растворенные газы. Однако для некоторых культур этот шаг был пропущен. При добавлении надосадочной жидкости к культурам E. lenta авторы наблюдали выработку прогестина только тогда, когда бактерии имели доступ к растворенным газам. Поскольку газообразный водород преобладает в кишечнике и вырабатывается EcN, Девлин предположила, что он может быть ключом к бактериальной конверсии глюкокортикоидов в прогестины. Чтобы проверить это, они добавили газообразный водород к E. lenta и наблюдали аналогичное количество выработки прогестинов. «Все мы испускаем газы, верно?» - говорит Девлин.
«Но открытие того, что выделение водорода на самом деле вызывает бактериальный метаболизм стероидов, стало для меня самым удивительным результатом этой работы».

Исследователи получили изображение ко-культуры Eggerthella lenta и E. coli Nissle с помощью электронной микроскопии. Фото: Megan McCurry, Harvard Medical School Electron Microscopy Facility.
Далее, используя сравнительный геномный анализ генома бактериальных штаммов, производящих прогестины и не производящих их, Девлин и ее группа выявили кластер из четырех генов, участвующих в этой реакции. Экспрессия этого кластера в бактериях, которые не могут превращать глюкокортикоиды в прогестины, позволила им это делать. «Это именно та работа, которая сейчас необходима в данной области», - считает Кларк. «У нас есть множество наблюдений за тем, как микробы воздействуют на хозяина, но нам не хватает необходимой степени точности, чтобы вмешаться и настроить ситуацию в свою пользу».
Другие группы показали, что уровень некоторых глюкокортикоидов, продуцирующих прогестины, в 5-10 раз выше у беременных женщин. Используя кал беременных и небеременных женщин, Девлин и ее сотрудники обнаружили, что увеличение концентрации глюкокортикоидов приводит к повышению уровня прогестинов, который в два раза выше у беременных женщин. Обогащение G. pamelaeae, E. lenta и кластера генов в этих образцах убедительно свидетельствует о том, что микробиом вносит свой вклад в высокий уровень прогестинов. Для дальнейшего изучения того, как микробиом вырабатывает повышенные уровни прогестинов во время беременности, ученые пересадили фекалии беременных мышей небеременным самкам мышей без микробиома и обнаружили высокий уровень прогестинов в фекалиях реципиентов. Пересадка этим мышам только E. lenta и EcN дала те же результаты.
«Одна из особенностей нашей работы заключается в том, что она ставит больше вопросов, чем дает ответов», - говорит Девлин. Она заинтересована в изучении долгосрочных образцов на протяжении всей беременности, чтобы выявить связь между микробиомом кишечника и уровнем послеродовой депрессии. К сожалению, отмечает Девлин, биобанк образцов кала трудно найти. «Я бы посоветовал врачам: рассмотрите возможность сбора кала у ваших пациентов», - добавила она.